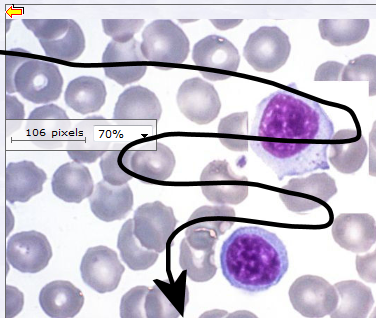

|
|
Slide 114: Blood smear
|
Wrights
|
|
This is a blood smear to demonstrate red and white blood cells.
|
Identify microscopically:
- Erythrocytes
Neutrophils Eosinophils Basophils Lymphocytes Monocytes
Draw and annotate:
The different blood cells and their distinguishing characteristics in detail.
Do the virtual differential white blood cell count.
Reflection:
- How are the different white blood cells distinguished from one another? Explain.
Differential White Cell Count
Step-by-step
- Preparation: Theory
- List the cellular components of blood.
- Describe the cellular components of blood.
- Review the characteristics of each of the WBC.
- Look up the normal range for each of the WBC.
- Use Image Search and find examples of the WBC.
- Preparation: Recording results
Prepare an A4 table to record your results.
|
Normal range = |
Image |
Drawing |
Description |
Seen |
Total |
% |
< = > |
| Neutrophils |
|
|
|
|
|
|
|
|
| Eosinophils |
|
|
|
|
|
|
|
|
| Basophils |
|
|
|
|
|
|
|
|
| Lymphocytes |
|
|
|
|
|
|
|
|
| Monocytes |
|
|
|
|
|
|
|
|
|
Total= |
Total= |
100% |
|
- Prepare to count
- Open the blood smear (slide 114).
- Get a feel.
- Start at the top left.
- Zoom to about 20% magnification.
- Scroll from left to right then right to left until you reach the end of the slide.
- Get a feel for the distribution of the WBC on the slide.

- Count
- Open the blood smear (slide 114).
- Do the count.
- Start at the top left.
- Zoom to about 60% magnification. Zoom higher when needed.
- Scroll from left to right then right to left until you reach the end of the slide.
- At each object on the slide, decide: artifact, platelets or WBC.
- Identify the specific type of WBC and add to your running count in the table.
- Calculate
- For each of the WBC, calculate the % of total.
- No of WBC ÷ Total WBC x 100 = %
- Compare your values to the normal values.
- All values should be within normal ranges.
If your values are not within the normal ranges, you have misdiagnosed your patient.
|